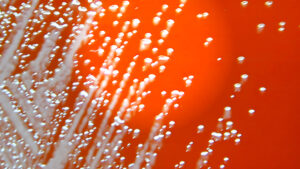
Misterio Médico: Brote de Melioidosis en Georgia Revela Conexiones Inesperadas

TimeCapsuleLLM: La IA que viaja en el tiempo
¿Imaginan una máquina del tiempo digital? Una que, sin cables ni circuitos complejos, nos lleve a desvelar los secretos mejor guardados del pasado con una precisión asombrosa ⏳. ¡Pues prepárense, porque un brillante estudiante de informática acaba de tropezar con algo así por accidente!
Un avanzado modelo de lenguaje de inteligencia artificial, bautizado como TimeCapsuleLLM, ha logrado reconstruir detalles históricos de las icónicas protestas de Londres de 1834, dejando a su creador, y a la comunidad científica en general, completamente fascinados.
TimeCapsuleLLM: La IA que viaja en el tiempo
Pero, ¿cómo funciona exactamente este prodigio tecnológico? La mente brillante detrás de este proyecto es Hayk Grigorian, un estudiante de informática con una visión única. Él entrenó a su modelo TimeCapsuleLLM con un conjunto de datos muy específico: ¡nada menos que textos de Londres datados entre 1800 y 1875!
Este conjunto de datos, que a primera vista podría parecer modesto con solo 6.25 GB, resultó ser el combustible perfecto para que la IA lograra algo verdaderamente asombroso. No estamos hablando de una inteligencia artificial cualquiera; es, literalmente, una ventana lingüística que se abre a otra era, ¡una cápsula del tiempo digital!
el descubrimiento inesperado de un eco del pasado
El verdadero «momento eureka» llegó cuando Grigorian lanzó una pregunta aparentemente sencilla a su creación: quería desentrañar los eventos más significativos de 1834 en Londres. La respuesta de TimeCapsuleLLM fue, para su sorpresa, ¡completamente inesperada!
El modelo no solo mencionó las protestas de 1834, sino que, para añadirle más misterio, ¡nombró a Lord palmerston! La curiosidad de Grigorian se disparó, y se lanzó de cabeza a investigar. Su asombro fue mayúsculo al confirmar la autenticidad de cada detalle que la IA había desvelado.
La precisión histórica: ¿Casualidad o inteligencia?
¡Y aquí es donde el asunto se pone realmente interesante! Las referencias de la IA no eran meras conjeturas. Las protestas de Londres de 1834 fueron un evento real, directamente vinculadas a la polémica Ley de Enmienda de la Ley de Pobres.
Lord Palmerston, una figura política clave de la época, también tenía una conexión innegable con estos acontecimientos. La habilidad de la inteligencia artificial para hilar todos estos detalles con un entrenamiento relativamente modesto es, simplemente, ¡espectacular! Es como si el modelo hubiera «entendido» el contexto histórico.
Implicaciones: Una nueva era para la historia
este asombroso «viaje digital en el tiempo» no solo abre una ventana, sino que nos catapulta a una nueva era para la investigación histórica y la educación. Imaginen el potencial si alimentamos a estos modelos con conjuntos de datos aún más masivos. Podríamos reconstruir contextos históricos con una granularidad y un nivel de detalle que, hasta ahora, eran impensables.
¿Alguna vez te has preguntado cómo vivía la gente común, qué comían o cómo sentían el pulso de eventos políticos específicos? TimeCapsuleLLM podría convertirse en nuestra herramienta definitiva. Es, literalmente, como tener a un historiador incansable y ultra-eficiente a nuestra disposición, ¡un verdadero chatbot del pasado!
Los matices: Cuidado con los sesgos históricos
Pero, ojo, no todo es un cuento de hadas digital. La IA, por muy sofisticada que sea, es siempre un espejo de los datos con los que se alimenta. Si los textos originales arrastran sesgos históricos o perspectivas limitadas, la inteligencia artificial los replicará sin pestañear.
Esto nos subraya la importancia crítica de la curaduría de datos y la imperiosa necesidad de un análisis crítico y, sobre todo, humano. la IA es,sin duda,una herramienta potentísima,pero jamás podrá reemplazar la mente aguda y el juicio experto del historiador.
El futuro está aquí,y es histórico
la habilidad de TimeCapsuleLLM para desenterrar y contextualizar eventos históricos es,sin duda,un hito monumental. Nos demuestra que la IA puede ser una aliada verdaderamente invaluable para desentrañar los misterios de nuestro pasado. Eso sí,siempre bajo la atenta supervisión de nuestra inteligencia humana,garantizando así la objetividad y la profundidad necesarias.
Es un recordatorio vibrante y emocionante de que el futuro de la historia no solo se escribe en libros, ¡sino que también se está reconstruyendo con algoritmos! ¿Qué otros secretos insospechados crees que la IA podría desvelar de nuestro pasado? ¡Nos encantaría leer tus ideas en los comentarios!
¡Sigue Tendencias Digitales para estar al día con lo último en tecnología y tendencias digitales!